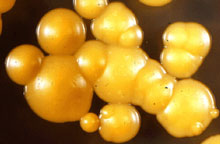

Plant Health Progress - Plant Health Reviews - 19 October 2000
Accession DOI:10.1094/PHP-2000-1019-01-RV
Copyright © 2000 Plant Health ProgressKevin McCluskey, Curator, Fungal Genetics Stock Center, University of Kansas Medical Center
|

Fig. 1. Photo courtesy Garry Platt.
|
|
The topic of ancient DNA, indeed the very existence of it, sparks both public imagination and scientific controversy. Although molecular genetic research on this topic has gone on since the mid 1980s, research using ancient remains has been conducted on mummies, plant remains, and fossils since the 1930s (2,4). Some of the early work was focused on determining food preferences of ancient populations and genetics of human populations. A symposium (Beyond Jurassic Park: Accessing Genetic Information Hidden in Herbaria and Archival Plant, Microbe, and Insect Specimens) held at the 1998 American Phytopathological Society’s annual meeting discussed what information is being gleaned from archival material.
Early Results
|

Fig. 2. The Quagga.
|
|
Recent efforts at analyzing ancient materials began with the cloning of DNA from an extinct zebra-like animal, the Quagga (9) (Fig. 2), and quickly advanced to cloning DNA from human mummies (14). In the first case, the specimen was over 100 years old; in the latter, the DNA was thousands of years old.
Although there was continued interest in isolating ancient DNA, there were technical problems that made the study of these molecules difficult. Chief among these were the findings that the ancient DNA is often damaged (14) (with the majority of the damage occurring immediately after death), and the statistical problems associated with analyzing clones, each having arisen from individual molecules. The development of the Polymerase Chain Reaction (PCR) (17) solved these problems to different degrees and has made possible many interesting and informative studies of ancient materials.
Shortcomings
Although PCR and direct sequencing of PCR products has overcome some of the technical problems associated with studying ancient or archival DNA, there remains serious resistance (3, 15) to accepting the results that have been proffered on evolutionary time scales. Some of these arguments are based on the theoretical stability of the DNA molecule under laboratory conditions, while others are based on the likelihood of introducing contemporary contaminants into the reactions. Scrupulous adherence to good laboratory practice can reduce the chance of introducing modern DNA, but only the weight of numerous successful studies will overcome the resistance based on the idea that DNA cannot survive millions of years. This is based upon the premise that DNA naturally degrades chemically at a predictable rate. This has been investigated (8) and it is clear that the rate of DNA degradation in solution is different from that seen under the conditions that allow DNA to survive millions of years. Recent work with mitochondrial DNA from Neanderthal remains (13), used to investigate the relationship among primate lineages, demonstrates the extent to which the studies with ancient DNA are being accepted in the scientific community.
Focus of the Symposium
The symposium held at the APS/ESA meeting looked at how phytopathologists and entomologists are applying the techniques developed to investigate ancient DNA to questions relevant to these disciplines. Among these, population genetics and epidemiology are the main goals of studies looking at genetic changes taking place over tens or hundreds of years. These studies do not have many of the problems facing studies looking at mummies or bacteria in amber and they are relatively straightforward to undertake. A number of such studies have been carried out in various fields. Among those topics not discussed at the 'Jurassic Park' symposium include the identification of tobamoviruses from Australia in 1899, Borrelia in British ticks from 1896, extinct and extant New Zealand wrens, and extinct wolves. Recent work has looked at short tandem repeats from ancient human skeletal material, the phylogenetic position of the extinct moa from Hawaii and Oak chloroplast DNA from ancient and modern specimens. Even though directed work of this type has been widely undertaken, other studies, such as that by Hummel et al. (10) defend the validity of using DNA from ancient sources.
The symposium did include talks describing isolation of DNA from bees in amber, from bacteria in bees in amber and isolation of bacteria from amber. We will hear about reproductive strategies in Phytophthora and Puccinia, about the use and value of museum specimens in mammalian and insect systems, and finally about using museum-curated flies for systematic studies.
Ancient Bacteria?
Among the scientists making the largest impact on the analysis of ancient DNA and even ancient organisms, Dr. R. Cano of the California Polytechnic State University has been a pioneer, unearthing DNA and even a living bacterial strain from bees in 20-45 million-year-old amber from the Dominican Republic (5, 6) (Figs. 3 and 4). There has been a significant amount of controversy surrounding the isolation and reviving of the ancient Bacillus (3, 15), but Dr. Cano's group has overcome most criticism and the validity of this discovery is well accepted. Although this work does not come close to the popular image of recovering life from ancient amber, it suggests that the accepted limits to the survival of DNA and even of organisms may need to be re-thought.
|
 |
|
Fig. 3. Courtesy R. J. Cano. |
Fig. 4. A bee in amber. Courtesy R. J. Cano. |
Plant Destroyer
Every plant pathologist knows of the terrible disease, late blight of potato, caused by Phytophthora infestans. Recent changes in the global distribution of this pathogen make it increasingly important to understand the biology of this organism. One way to do that is to look at specimens that were collected before the mass movement of plant materials common in the practice of modern agriculture. Dr. Jean Beagle Ristaino of the Department of Plant Pathology at North Carolina State University, Raleigh has done just that. Her talk, and a recent review in Phytopathology (16), described the possibility of studying the genetics of this important pathogen using materials from archives and herbaria. Important questions addressed by this and related studies include whether sexual reproduction was occuring in Europe when the pathogen was first detected there and when both mating types were introduced into Europe (16).
Rust Dynamics
|

Fig. 5. Urediniospores and a teliospore of Puccinia grindeliae. |
|
If you could go back in time and sample a stem rust population before the barberry eradication programs, what would you find? This type of study may be possible using herbarium materials. A similar project aimed at understanding the population genetics of Puccinia grindeliae (11, 12) (Fig. 5), a potential biological control agent, was carried out by Dr. Craig Liddell, now at Paradigm Genetics, and his colleagues at New Mexico State University.
Te1iospores from naturally infected plant material were used to amplify the Intervening Transcribed Spacer of the ribosomal RNA genes. Although their herbarium samples yielded different success rates, the overall findings of this study support the observation that this fungus reproduces primarily by sexual reproduction and has done so prior to the introduction of intensive agriculture into the region.
Do It Yourself
While the value of museum specimens for public appreciation and even for systematic study has been long acknowledged, the use of museum specimens for paleogenetic studies is relatively new and as such the approaches to using these specimens and for analyzing the data generated with these studies is still in its development. Dr. Rob DeSalle of the American Museum of Natural History and author of the book, "The Science of Jurassic Park and The Lost World" (1997, Basic books), spoke about several studies using different organisms. His talk described how the use of museum specimens can help shed light on different evolutionary and population genetic questions relevant to the interaction of human activity and the environment. In addition to being an author of popular books, Dr. DeSalle is an entomologist and has investigated the phylogenetic impact of DNA from amber-preserved specimens (7).
Fly in the Ointment
|

Fig. 6. A black fly.
|
|
Finally, Dr. J. William Ballard of the Field Museum of Natural History described how the method of preparing specimens for museums affected the ability to later extract DNA suitable for genetic studies. Dr. Ballard's research aims to unite the studies of the pattern and the process of evolution and as such curated materials play an important role. His research has delved into questions of whether the mitochondrial genome (1) is a useful molecular marker for phylogenetic research. Additional work has looked at more worldly traits including features of traps for catching blackflies, determining the gender of blackflies (Fig. 6), and horsefly feeding strategies.
Overall, the techniques developed to analyze ancient DNA are finding their way into wider applicability. The careful preservation of materials in herbaria and other biological collections provides an opportunity to delve into the
otherwise impenetrable past.
Further Reading
DeSalle, R. and Lindley, D. The Science in Jurassic Park. Basic Books, New York: 1997
Paabo, S. Ancient DNA. Scientific American. November 1993: 86-92
References
1. Ballard, J. W., Hatzidakis, J., Karr, T. L., and Kreitman, M. 1996. Reduced variation in Drosophila simulans mitochondrial DNA. Genetics 144:1519-28.
2. Barton-Wright, E. C., Booth, R. G., and Pringle, W. J. S. 1944. Analysis of barley from king Tutankhamun's tomb. Nature 153:288.
3. Beckenbach, A. T. 1995. Age of bacteria in amber (letter). Science 270:2015-2016.
4. Boyd, W. C. and Boyd, L. G. 1937. Blood group testing on 800 mummies. Journal of Immunology, 32:307-316.
5. Cano, R. J. and Borucki, M. K. 1995. Revival and identification of bacterial spores in 25- 40-million-year-old Dominican amber. Science 268:1060-1064.
6. Cano, R. J. 1995. Age of bacteria in amber (Response). Science 270:2016-2017.
7. DeSalle, R., Gatesy, J., Wheeler, W., and Grimaldi, D. 1995. DNA Sequences from a fossil termite in Oligio-miocene amber and their phylogenetic implications. Science 257:1933-1936.
8. Handt, O., Hoss, M., Krings, M., and Paabo, S. 1994. Ancient DNA: methodological challenges. Experientia 50:524-529.
9. Higuchi, R., Bowman, B., Freiberger, M., Ryder, O. A., and Wilson, A. C.. 1984. DNA sequences from the Quagga, an extinct member of the horse family. Nature 312:282-284.
10. Hummel, S., Herrmann, B., Rameckers, J., Muller, D., Sperling, K. Neitzel, H., and Tonnies, H. 1999. Proving the authenticity of ancient DNA by comparative genomic hybridization. Naturwissenschaften 86:500-503.
11. Liddell, C. M., Waddell, C. A., and McEntee, J. P. 1993. Teliospore germination in Puccinia grindeliae, rust of the rangeland weed Gutierrezia sarothrae. Plant Disease 77:149-152.
12. Liddell, C. and Waugh, K. O. 1996. PCR amplification of ITS rDNA from rust teliospores collected on southwestern rangeland from 1907 to 1995. Fungal Genet News 143:37-38.
13. Ovchinnikov, I. V., Götherström, A., Romanova, G. P., Kharitonov, V. M.,,Lidén, K., and Goodwin, W. 2000. Molecular analysis of Neanderthal DNA from the northern Caucasus. Nature 404:490-493.
14. Paabo, S. 1985. Molecular cloning of ancient Egyptian mummy DNA. Nature 314:644-645.
15. Priest, F. G. 1995. Age of bacteria in amber (letter). Science 270:2015.
16. Ristaino, J. B. 1998. The importance of archival and herbarium materials in understanding the role of oospores in late blight epidemics of the past. Phytopathology 88:1120-1130.
17. Saiki, R. K., Gelfand, D. H., Stoffel, S., Scharf, S. J., Higuchi, R., Horn, G. T., Mullis, K. B., and Erlich, H. A. 1988. Primer-directed enzymatic amplification of DNA with a thermostable DNA polymerase. Science 239:487-491.
